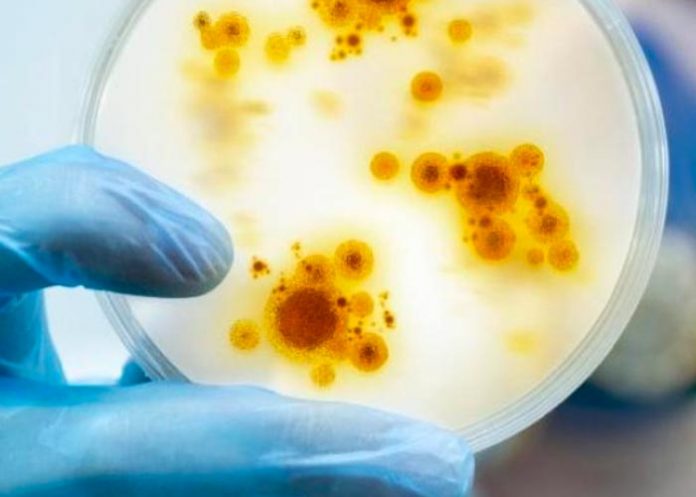
Uruguay recordó a población consultar prestador de salud

Este viernes el Ministerio de Salud Pública (MSP) de Uruguay confirmó el descubrimiento en Montevideo del primer caso de viruela del mono en el país suramericano.
Dicha confirmación se llevó a cabo por la técnica de PCR, y es el único en el país; informó el MSP en un comunicado.
A su vez detalló «el paciente, que se encuentra estable y en aislamiento, tiene antecedente de viaje en los últimos días».
«En línea con las recomendaciones de la OPS/OMS, se inició la identificación y seguimiento de todos los contactos por parte del equipo del Departamento de Vigilancia en Salud»; amplió el MSP. Por el momento no se han identificado nuevos casos sospechosos en relación con este caso; puntualizó la cartera sanitaria.
Uruguay recordó a población consultar prestador de salud

Así mismo, el MSP recordó a la población que «ante síntomas relacionados con la viruela símica, consulte a su prestador de salud». También se señaló que el paciente consultó en la mutualista por síntomas de diarrea y malestar general, sin afecciones en la piel.
Al principio, el caso se trató como una infección digestiva común. “Sí se vio que era un caso que había estado fuera del país y entonces nosotros tenemos un equipo de seguimiento, por los pacientes que salen de alta tanto de puerta de emergencia como del sanatorio”; manifestó y añadió que ese equipo llamó al hombre después de la consulta.
Entonces, el paciente expresó que tenía síntomas en la piel. Se le solicitó que enviara fotos al celular de la persona de la mutualista que lo atendía, y se llevaron a cabo todos los protocolos establecidos y comunicación al MSP, resaltó Rodríguez.
Finalmente, el Ministerio “hizo las tomas de muestra correspondiente en el día de ayer y hoy se confirmó la asistencia en ese paciente de este virus”; concluyo.
COMUNICADO | El Ministerio de Salud Pública informa el hallazgo del primer caso importado de viruela símica (o viruela del mono) en Montevideo. La confirmación se llevó a cabo por la técnica de PCR y es el único en el país. pic.twitter.com/TedxnC074P
— MSP – Uruguay (@MSPUruguay) July 29, 2022
Tomado de: telesurtv.net